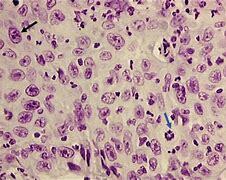
the black reaction

-
robert hooke was the english physicist came up with the first description of a cell. this is important because this description helped people understand that cells are mandatory for all living organisms
-
 the microscope allowed people to get a glimpse into the microscopic world. this event is important because microscopes allow biologists to get a closer and defined look at cells and other things that cant be seen with the naked eye.
the microscope allowed people to get a glimpse into the microscopic world. this event is important because microscopes allow biologists to get a closer and defined look at cells and other things that cant be seen with the naked eye. -
robert brown was a scottish botanist recognized the nucleus as an essential of living cells. this is important because today the nucleus is considered the most important cell.
-
albert kolliker showed that cells are formed through scissions of pre-existing cells. this is important because this allows people to understand how cells can be formed
-
 cell theory states that living organisms are made form cells. this is important because knowing cells are in all living organisms help us understand how organisms are created, formed, and how they die
cell theory states that living organisms are made form cells. this is important because knowing cells are in all living organisms help us understand how organisms are created, formed, and how they die -
 karl deiters published posthumously which contains descriptions and drawings of nerve cells studied by using histological methods and microdissections made with thin needles under the microscope. this is important because it gives biologists and people a visual representation of cells.
karl deiters published posthumously which contains descriptions and drawings of nerve cells studied by using histological methods and microdissections made with thin needles under the microscope. this is important because it gives biologists and people a visual representation of cells. -
 oil immersion lenses developed the microtome technique and the use of new fixing methods and dyes that improved microscopy. this is important because this increased the power of a microscope
oil immersion lenses developed the microtome technique and the use of new fixing methods and dyes that improved microscopy. this is important because this increased the power of a microscope -
 josepth gerlach, a german histologist expanded kollikers view and proposed that in all of the central nervous system nerve cells established anastomoses with each other through a network formed by the minute branding of their dendrites
josepth gerlach, a german histologist expanded kollikers view and proposed that in all of the central nervous system nerve cells established anastomoses with each other through a network formed by the minute branding of their dendrites -
golgi developed the black reaction. this is important because it helps people who research cells have a better study of the nervous system and how it develops
golgi developed the black reaction. this is important because it helps people who research cells have a better study of the nervous system and how it develops -
 waldeyer introduced the term numerous to indicate independent nerve cells. this is important because it gives biologists a more scientific term to nerve cells
waldeyer introduced the term numerous to indicate independent nerve cells. this is important because it gives biologists a more scientific term to nerve cells
Want to make a timeline like this?
Use Timetoast to turn dates, events, milestones, and phases into a clear visual timeline you can build and share. Timetoast is a timeline maker for work, school, research, and stories.